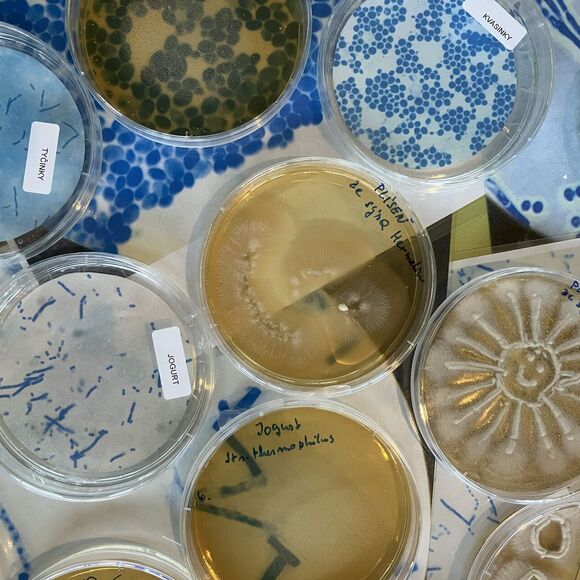

Děti se stávají agenty fermentace a jejich úkolem je zastavit šíření tzv. Zmatkobakterií, které zkreslují informace o potravinách a výživě. Během jedné společné mise postupně odhalují, jak mikroorganismy pomáhají měnit běžné suroviny v bezpečné a prospěšné potraviny, a učí se rozlišovat mýty od faktů.
Program je připraven ve dvou úrovních obtížnosti:
-
junior – pro 1. stupeň ZŠ
-
senior – pro 2. stupeň ZŠ
Obě varianty pracují se stejným příběhem a stanovišti, liší se však hloubkou úkolů a náročností vysvětlení.
Jak hra probíhá
Žáci pracují ve skupinách a s pomocí mapy muzea a pracovních listů plní úkoly na jednotlivých stanovištích. Za každý splněný úkol získávají symboly k rozluštění hádanky, které je dovedou až k záchraně „Knihy superjídla“. Úspěšní účastníci obdrží certifikát agenta fermentace.
Stanoviště a obsah
Program kombinuje:
-
odborná stanoviště (řízená, pro celou třídu) zaměřená na mikroorganismy, fermentaci a výživu
-
muzejní pátrací stanoviště, na kterých se děti věnují bezpečnosti potravin, kvalitě, historii fermentace, cestě potraviny a mikroorganismům kolem nás
Časová náročnost:
-
odborná stanoviště – 50 minut
-
muzejní pátrací stanoviště – děti stanoviště procházejí samostatně – 60 minut
Pořadí stanovišť není podstatné, děti mohou začít buď na odborném, nebo na pátracím stanovišti.
Přínos programu
-
rozvoj kritického myšlení a práce s informacemi
-
pochopení základů fermentace, mikrobiologie a výživy
-
propojení vědy, historie a každodenního života
-
aktivní a hravou formou podporuje zájem o zdravé stravování
Program připravujeme ve spolupráci s Výzkumným ústavem mlékárenským, společností Milcom, Českou zemědělskou univerzitou a Národním centrem zemědělského a potravinářského výzkumu.